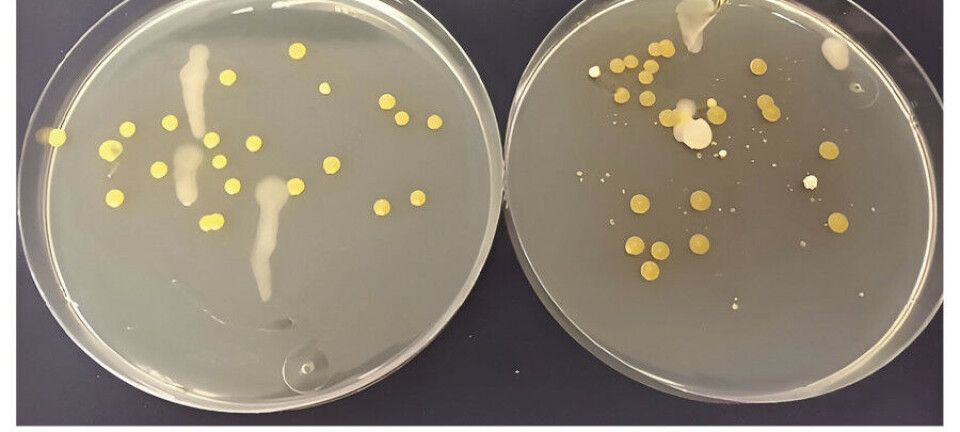

FAG Oversiktsartikkel
Diagnostikk av irritabel tarmsyndrom – finnes det gode biomarkører?
Hovedbudskap
- Diagnosen irritabel tarmsyndrom baseres på typiske symptomer, etter at andre sykdommer er utelukket. Det er ønskelig med en diagnostisk biomarkør som kan bekrefte diagnosen.
- Selv om det har vært lagt ned et stort forskningsarbeid har man i dag ingen biomarkør som egner seg for bruk i klinikken.
- Videre forskning vil forhåpentligvis komme frem til en kombinasjon av symptomer og et begrenset antall biomarkører som kan bekrefte diagnosen.
Diagnostikk av irritabel tarmsyndrom _ finnes det gode biomarkører.pdf(147 KB)
Irritabel tarmsyndrom (Irritable Bowel Syndrome, IBS) er en hyppig forekommende funksjonell mage-tarm-lidelse (Functional Gastrointestinal Disorder, FGID). Diagnosen baseres på typiske symptomer etter utelukkelse av organisk sykdom og blir derfor ofte en utelukkelsesdiagnose. Det er et utbredt ønske om å identifisere en eller flere biomarkører som kan bekrefte diagnosen (1). Denne artikkelen gir en oversikt over mulige diagnostiske biomarkører for IBS.
Materiale og metode
Artikkelen er en oversikt basert på litteratursøk i PubMed. Det er ikke en formell metaanalyse eller fullstendig systematisk gjennomgang, men forfatterens vurderinger av litteraturen basert på erfaringer med pasientgruppen og egen forskning på området.
Funksjonelle mage-tarm-sykdommer
FGID er symptomer fra mage-tarm-kanalen, slik som magesmerter, kvalme, oppkast, diaré og forstoppelse uten kjent årsak og hvor selv en grundig utredning ikke kan påvise strukturelle eller patologiske forandringer. Diagnosen baseres på typiske symptomer etter at organisk sykdom er utelukket. Det er laget et internasjonalt klassifikasjonssystem for FGID, de såkalte Roma-kriteriene, som definerer 22 forskjellige FGID hos voksne og 10 hos barn/ungdom. Kriteriene blir regelmessig revidert. Siste versjon er Roma IV som ble publisert våren 2016.
FGID beskrives som en bio-psyko-sosial lidelse. Men det betyr ikke at psykososiale faktorer fører til somatisk sykdom eller motsatt. Modellen forklarer det gjensidige avhengighetsforholdet mellom psykiske faktorer, sosiale forhold og organisk sykdom, og forkaster den todelte tenkningen om at en sykdom enten er psykisk eller somatisk.
FGID er hyppige lidelser, med rapporterte prevalenstall så høye som 62% (2). Det betyr at grensen til normalplager er uklar. De fire hyppigste FGID er funksjonell brystbrann, funksjonell dyspepsi, IBS og forstoppelse. Denne artikkelen begrenser seg til IBS.
Irritabel tarmsyndrom (IBS)
IBS forekommer i de fleste land og kulturer med en prevalensrate på 11,2% (95% CI 9,8 – 12,8%) (3). IBS er karakterisert ved kroniske eller stadig tilbakevendende smerter/ubehag i magen relatert til endringer i enten avføringskonsistens eller hyppighet. Rammen viser de formelle Roma IV-kriteriene.
IBS er hyppigst hos kvinner og hyppigere hos yngre enn eldre. Typisk for tilstanden er at personene ofte i tillegg har andre lidelser (komorbiditet), slik som fibromyalgi og andre muskel/skjelett-smerter, tretthet og psykiske symptomer (angst og depresjon). Grad av symptomer varierer. De fleste har lette til moderate plager som grenser til normalplager som i liten grad påvirker allmenntilstanden og daglige gjøremål, mens andre har betydelige plager. IBS er assosiert med nedsatt livskvalitet i samme grad som mange somatiske sykdommer, og med betydelige direkte og indirekte helsekostnader.
Etiologi og patogenese er ukjent, men patofysiologiske forandringer påvises hos grupper av pasienter. Endringer i tarmens motilitet og sensitivitet, aktivering av immunologiske reaksjoner, forstyrrelser i hjernens funksjon, endret tarmpermeabilitet, endret tarmflora (fekal dysbiose), har alle vært assosiert med IBS. De påviste patofysiologiske endringene er forsøkt brukt som diagnostiske biomarkører.
Diagnosen baseres på de typiske magesymptomene. Fordi komorbiditet er hyppig, vil tilstedeværelsen av tilleggssymptomer støtte diagnosen. Symptomene kan sammen med klinisk undersøkelse og en enkel screening av blodprøver, urin og avføring, være tilstrekkelig for å stille diagnosen. Men ofte vil man føle behov for en større utredning for å utelukke annen sykdom som kan gi lignende symptomer, f.eks. cøliaki, mikroskopisk kolitt, kronisk inflammatorisk tarmsykdom (ulcerøs kolitt og Morbus Crohn) og kreft. Man skal være spesielt oppmerksom på alarmsymptomer, som blod i avføringen, jernmangelanemi, ufrivillig vekttap, cancer i familien, feber og debutalder over 50 år, som alle krever en videre utredning. Hensikten med enhver utredning er å utelukke andre sykdommer. Det finnes ingen test som positivt forteller at en pasient har IBS, tester kan bare utelukke annen sykdom. Det er et utbredt ønske om å finne en eller flere biomarkører som alene, eller i kombinasjon, kan skille IBS fra friske med normalplager, og fra pasienter med en organisk sykdom som gir de samme symptomene.
Biomarkører
Biomarkør er definert som «Et karakteristikum som er objektivt målt og vurdert som en indikator på en normal biologisk prosess, patologisk prosess eller farmakologisk svar på en terapeutisk intervensjon» (4). En god biomarkør skal være enkel i bruk og akseptabel for pasientene, ha høy reproduserbarhet, lav variabilitet innen definerte pasientgrupper, diskriminere godt mellom grupper og helst være billig. Subjektive, pasientrapporterte symptomer omtales av og til som biomarkører. Slike subjektive biomarkører viser ofte større variabilitet og er derfor mindre egnet.
En biomarkørs egenskaper avhenger av hvilken referansestandard (gullstandard) man sammenligner med, målet med testen og i hvilken populasjon biomarkøren er undersøkt. Det er flere bruksområder for biomarkører; 1) diagnostisk test for en tilstand, 2) predikasjon av sykdomsstadium, 3) risiko eller prognose og 4) valg av behandling og oppfølging av behandlingseffekt.
Biomarkører ved IBS
Vurderinger av biomarkører for IBS er utfordrende. For det første finnes det ingen gullstandard for IBS. Det er ikke mulig rent vitenskapelig å «bevise» at en pasient har sykdommen. Diagnosen baserer seg på typiske symptomer etter utelukkelse av andre tilstander. Hva som er typiske symptomer, har endret seg over tid. I dag er det Roma IV-kriteriene som er gjeldende. Det er heller ikke enighet om hvor omfattende utredning pasientene skal gjennom før andre sykdommer er utelukket. Det nærmeste vi kommer en gullstandard er symptomer som tilfredsstiller Roma IV-kriteriene etter at sykdommer som cøliaki, matallergi, kronisk inflammatorisk tarmsykdom (ulcerøs kolitt, Morbus Crohn og mikroskopisk kolitt), kreft og muligens gallesyre-indusert diaré er utelukket.
Et annet problem er at IBS trolig omfatter flere sykdommer. Postinfeksiøs IBS (P-IBS) som oppstår etter en mage-tarm-infeksjon er trolig en egen type. Matutløst IBS kan være en annen. Selv om matallergi skal utelukkes før diagnosen IBS stilles, er matintoleranse vanlig hos denne pasientgruppen. En kost med lavt innhold av FODMAP (fermentable oligo-, di-, monosaccharides and polyols) lindrer symptomene hos noen pasienter. Ikke-cøliaki-glutensensitivitet diskuteres som en annen årsak. IBS deles også inn i undergrupper basert på hovedsymptomene; diaré-dominert IBS (IBS-D), forstoppelses-dominert IBS (IBS-C), blandet IBS (IBS-M) og uspesifisert IBS (IBS-U). Diagnostisering av de forskjellige typer/grupper IBS kan kreve forskjellige biomarkører.
Et tredje problem er formålet med den diagnostiske biomarkøren. De samme biomarkørene kan neppe brukes til å skille IBS fra organisk sykdom og til å skille IBS fra friske personer med normalplager.
Spesifikke IBS biomarkører
Det relativt høye antall nye oversiktsartikler og metaanalyser viser den store interessen for temaet (5-8). Tabell 1 viser en oversikt over aktuelle biomarkører som omtales i denne artikkelen.
Tabell 1: Oversikt over aktuelle biomarkører for IBS
| Blodprøver | Tarmfunksjon | Cerebrale funksjoner | Fekale markører | Tarmvegg | Psykologiske symptomer |
| Inflammasjonstester (CRP, SR) | Motilitetsendringer | Bildediagnostikk (funksjonell MR, DTI og PET-scan) | Inflammasjonsmarkører (kalprotektin, laktoferrin, proteaser) | Celler og immunmarkører | Angst / depresjon |
| Immunologiske markører (interleukiner, cytokiner) | Sensitivitetsendringer | Endokrine markører (graniner) | Tarmveggens tykkelse | Livskvalitet | |
| Større testpaneler | Tarmpassasjetid | Tarmfloraens sammensetning | Tarmveggens permeabilitet | Stress | |
| Genetiske tester | Tarmfloraens funksjon (kort-kjedede fettsyrer) | ||||
| (Nevro)endokrine markører (serotonin-metabolisme, graniner, hypotalamus-hypofyse-binyreaksen) | Gallesyremalabsorpsjon |
Blodprøver
Nytten av biomarkører i blod er undersøkt i flere store studier og oppsummert i de nevnte oversikter og metaanalyser. Enkle inflammasjonsmarkører som CRP og SR skiller ikke IBS fra friske, men CRP-verdier ≤ 0,5 kan sannsynligvis utelukke kronisk inflammatorisk tarmsykdom (9). To store studier har undersøkt paneler bestående av 10 og 24 biomarkører for å skille IBS fra friske (10,11). Resultatene var skuffende. I arbeidet til Jones og medarbeidere var 14 genetiske markører inkludert (11). Selv om et betydelig antall gener har vært assosiert med IBS bidrar hver av dem bare til patofysiologien hos 1-5% av pasientene, og synes derfor uegnet som enkeltstående biomarkører (12). Den diagnostiske presisjon kunne økes noe ved å legge til psykologiske variabler (10,11). Komplekse markører bestående av en kombinasjon av mange enkeltmarkører, gjør testene lite anvendelige i praksis, og bruk av subjektive markører som psykologiske variabler, reduserer påliteligheten. Det har vært store forventninger til immunologiske markører, slik som cytokiner, men funnene har vært motstridende (13,14). Det kan synes som om en økning av Tumor Nekrose Faktor (TNF) og reduksjon av Interleukin 10 (IL10) er et funn som går igjen, men de er neppe egnet som diagnostiske biomarkører (15). Endringer i serotoninmetabolismen hos pasienter med IBS er sett i mange studier, og markører for serotoninmetabolismen, slik som kynurenin/tryptofan-ratio har vært foreslått (16). Denne og andre nye markører som lanseres som velegnede for IBS eller undergrupper av IBS, trenger ytterligere validering før de finner sin plass i klinikken. Endokrine funksjoner, spesielt hypotalamus-hypofyse-binyre-aksen, har vist seg å være for uspesifikke for diagnostikk av IBS, og resultatene har vært motstridende. Konklusjonen i dag er at vi ikke har en biomarkør, eller en kombinasjon av biomarkører i blod, som er bedre egnet enn symptombaserte kriterier for å skille IBS fra friske (17).
Blodprøver for å skille IBS fra organisk sykdom må tilpasses sykdommen vi vil utelukke. Normalverdier for CRP og SR utelukker sannsynligvis kronisk inflammatorisk tarmsykdom. Cøliaki kan utelukkes ved vevstransglutaminase-antistoff og eventuelt endomysium-antistoff og HLA DQ2/DQ8-genotyping. Matallergi kan utelukkes ved IgE-antistoff og hudtester (9).
Tarmfunksjon
Motilitetsforstyrrelser er velkjent hos pasienter med IBS, og tilstanden har også blitt kalt «spastisk kolon». Målinger av tynntarm- og tykktarmsmotilitet gjøres med trykkmåler (manometri). Endret trykk og elastisitet i endetarmen er et annet karakteristisk funn hos pasienter med IBS og måles med et barostat. Begge metoder har vist seg mindre egnet som diagnostiske biomarkører (7).
Endringer i passasjetid i tykktarmen måles relativt enkelt med røntgentette markører eller isotop-metoder. Resultatet korrelerer godt med avføringens form og hyppighet, men ikke med smerte og effekt av behandling (7).
Økt følsomhet (hypersensitivitet) i endetarmen og tykktarmen er vanlig hos pasienter med IBS. Sensitiviteten kan undersøkes med barostat og metoden ble lansert som en meget velegnet biomarkør for IBS. Men hypersensitivitet er mindre prevalent enn antatt (en studie viste at 21% hadde økt sensitivitet og 17 hadde nedsatt sensitivitet) og endres over tid, selv om IBS-symptomene er uendret. Metoden er derfor ikke egnet som biomarkør (18,19). Sensitivitet og spesifisitet for sensitivitetsmålinger er i størrelsesorden 63-96% og 71-90% (7).
Måling av motilitet, trykk og sensitivitet med manometri og barostat er dessuten invasive prosedyrer som krever kostbart utstyr som bare er tilgjengelig ved spesialiserte enheter. De er derfor uegnet som diagnostiske biomarkører i vanlig klinisk arbeid.
Fekale biomarkører
Flere fekale markører har vært vurdert som biomarkører for IBS. Kalprotektin og laktoferrin frigjøres fra aktiverte granulocytter i tarmslimhinnen, og spesielt kalprotektin skiller IBS fra inflammatorisk tarmsykdom, men kan ikke benyttes for å skille IBS fra friske (9).
Graniner er proteiner som skilles ut fra nevroendokrine celler i mage-tarm-kanalen. Forhøyede verdier av kromogranin A og sekretogranin II og III, og redusert nivå av kromogranin B, har i en studie vist seg å kunne skille IBS fra friske personer, men er ikke undersøkt hos pasienter med organisk sykdom (20). Fekale serinproteaser og 48-timers måling av gallesyrer i feces er andre biomarkører som foreløpig mangler god dokumentasjon (7).
Den fekale bakteriefloraens (mikrobiota) betydning for sykdommer generelt, og mage-tarm-sykdommer spesielt, har fått stor oppmerksomhet den senere tid. Kommunikasjon mellom tarmen og hjernen (den såkalte tarm-hjerne-aksen) er delvis formidlet via tarmfloraen. Det er i mange studier funnet en unormal fekal mikrobiota (dysbiose) hos pasienter med IBS, men til tross for stor forskningsaktivitet og mange publikasjoner, synes konklusjonen å være at det ikke er påvist forandringer som er spesifikke for IBS eller typer av IBS (21,22). Det er nylig lansert en norsk test for fekal dysbiose som kan være en biomarkør for IBS (23). Testen bør valideres bedre før den tas i rutinemessig bruk.
Tarmfloraens funksjon er trolig like viktig som sammensetningen. Bakteriene metaboliserer ufordøyelige polysakkarider og proteiner til kort-kjedede fettsyrer (SCFA), som har immunologiske og regulerende funksjoner i mage-tarm-kanalen. De er også viktige kommunikasjonsledd mellom tarmen og mikrobiota - og mellom tarmen og hjernen (24). SCFA har vist seg som lovende biomarkører for å skille IBS fra friske (25).
Tarmveggen
Det er rapportert endringer i flere celletyper i tarmveggen, slik som mastceller og T- og B-lymfocytter, og det er vist endringer i slimhinnens cytokinproduksjon. Enkelte studier vektlegger den anatomiske nærheten mellom cellene og tarmens nervesystem. Resultatene har så langt ikke blitt funnet egnet som biomarkører for IBS (7). El-Sahly og medarbeidere i Bergen har publisert arbeider som viser at tettheten av kromogranin A-celler i tolvfingertarmen, og tettheten av Peptid YY- og Somatostatin-celler i endetarmen, er egnede biomarkører (26,27). Ulempen er at det kreves endoskopi med spesialfarging av biopsier.
Veggtykkelse i tykktarmen målt med transvaginal ultralyd har også vist lovende resultater i en undersøkelse (5).
Tarmpermeabilitet kan evalueres ved målinger av laktulose og mannitol i urinen etter peroralt inntak, eller ved blodprøver som zonulin. Flere studier har vist økt tarmpermeabilitet hos pasienter med IBS, men konklusjonen synes å være at permeabilitet ikke er en uavhengig prediktor for IBS (28).
Cerebrale funksjoner
IBS er en bio-psyko-sosial lidelse hvor tarm-hjerne-kommunikasjonen er vesentlig. Kartlegging av hjernen med funksjonell MR, DTI (diffusion tensor imaging) og PET-skanning, har vist signifikante funksjonelle forskjeller som tyder på unormal hjerneaktivitet som delvis er avhengig av komorbiditet (angst og depresjon) (7,29). Slike undersøkelser vil neppe kunne anvendes som diagnostiske biomarkører, men kan kanskje brukes for å predikere respons på antidepressiv behandling og kognitiv terapi, som vi vet er god behandling for enkelte pasienter med IBS.
Psykologiske markører
Flere studier har vurdert psykologiske markører som angst, depresjon, stress og livskvalitet, enten alene eller kombinert med symptomer og biologiske markører. Generelt er psykologiske biomarkører mindre egnede på grunn av stor interindividuell variasjon og variasjon over tid, og resultatene er sprikende (5).
Konklusjon
Selv om symptombaserte diagnostiske biomarkører (Roma-kriteriene) er mangelfulle og derfor revideres med mellomrom, er de fortsatt bedre enn tilgjengelige, objektivt målbare markører. Fordi det er et stort behov for en pålitelig og klinisk anvendelig biomarkør, har det vært stor forskningsaktivitet på området. Forskningen har gitt oss verdifull kunnskap om IBS, men ingen klinisk anvendelig biomarkør for å skille IBS fra friske. Tilgjengelige biomarkører for å skille IBS fra annen sykdom er mer pålitelige, men må rettes spesifikt mot sykdommen man vil utelukke. Det er å håpe at man i fremtiden vil utvikle en biomarkør som anvender symptomer og en kombinasjon at et begrenset antall objektivt målbare markører, for å stille en positiv IBS-diagnose.
Interessekonflikter
Ingen.
FAG Kronikk: Bakteriefloraen i tarmen - kunnskap og myter